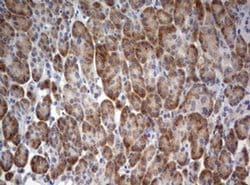
STK11 Mouse anti-Human, Clone: OTI0A3, liquid, TrueMAB 100 &mu;L | Buy Online | Origene Technologies | Fisher Scientific

missing translation for 'onlineSavingsMsg'
Learn More
Learn More
STK11 Mouse anti-Human, Clone: OTI0A3, liquid, TrueMAB™

Descripción
LKB1 (also known as STK11 - Serine/threonine-protein kinase STK11), a member of the serine/threonine kinase family, is a tumor suppressor. LKB1 physically associates with p53 and regulates specific p53 dependent apoptosis pathways. LKB1 is present in both the cytoplasm and nucleus of living cells and translocates to mitochondria during apoptosis. LKB1 functions as a master upstream protein kinase, regulating AMPK related kinases as well as AMPK. Mutations in LKB1 gene are associated with Peutz Jeghers syndrome.
Especificaciones
Especificaciones
| Antígeno | STK11 |
| Aplicaciones | Immunohistochemistry (Paraffin), Western Blot |
| Clasificación | Monoclonal |
| Clon | OTI0A3 |
| Concentración | 1 mg/mL |
| Conjugado | Unconjugated |
| Formulación | PBS with 1% BSA, 50% glycerol and 0.02% sodium azide |
| génica | STK11 |
| N.º de referencia del gen | Q15831 |
| Alias de gen | LKB1, PJS, hLKB1 |
| Mostrar más |
Título del producto
Al hacer clic en Enviar, acepta que Fisher Scientific se ponga en contacto con usted en relación con los comentarios que ha proporcionado en este formulario. No compartiremos su información para ningún otro fin. Toda la información de contacto proporcionada se mantendrá de acuerdo con nuestra Política de Privacidad. Política de privacidad.
¿Detecta una oportunidad de mejora?